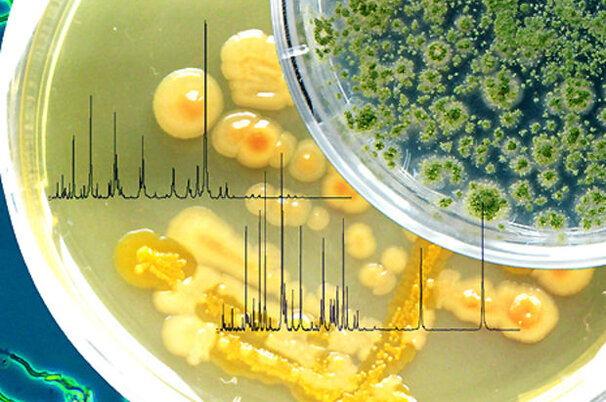

Artikel werden durchsucht.
Tiere
Übrige Tiere
Studie: Ratten helfen ihren gefangenen Freunden
Tiere
Tiergesundheit
Mit Pflanze gegen Parasiten bei Schafen und Ziegen
Vermischtes
Allerlei
«Bauer, ledig, sucht…»: Bekommt Nicole ein Baby und Corinne ein Dromedar?
Pflanzen
Spezialkulturen
Weinbauern von starkem Franken hart getroffen - Klausel gefordert
Vermischtes
Allerlei
Bündner Regierung unterstützt Ausbau des Skigebiets am Oberalppass
Politik & Wirtschaft
Agrarwirtschaft
Weltmarkt: Lebensmittelpreise sinken
Vermischtes
Allerlei
Forschung: Krankheitserreger rascher auf Lebensmittel erkennen
Vermischtes
Marktmeldungen
Weihnachtsstimmung ist arg getrübt
Politik & Wirtschaft
Agrarpolitik
(Noch) kein Durchbruch am Weltklimagipfel
Politik & Wirtschaft
Agrarpolitik
Thurgau: Herzlicher Empfang für Nationalratspräsident Walter
Das Wetter heute in
Lesershop
Umfrage

Wer macht die Büroarbeiten für den Hof?
- Hauptsächlich der Mann:49.28%
- Hauptsächlich die Frau:36.23%
- Beide zusammen:4.35%
- Ist nicht klar geregelt:10.14%
Teilnehmer insgesamt: 276
Bekanntschaften
Suchen Sie Kollegen und Kolleginnen für Freizeit und Hobbies? Oder eine Lebenspartnerin oder einen Lebenspartner?